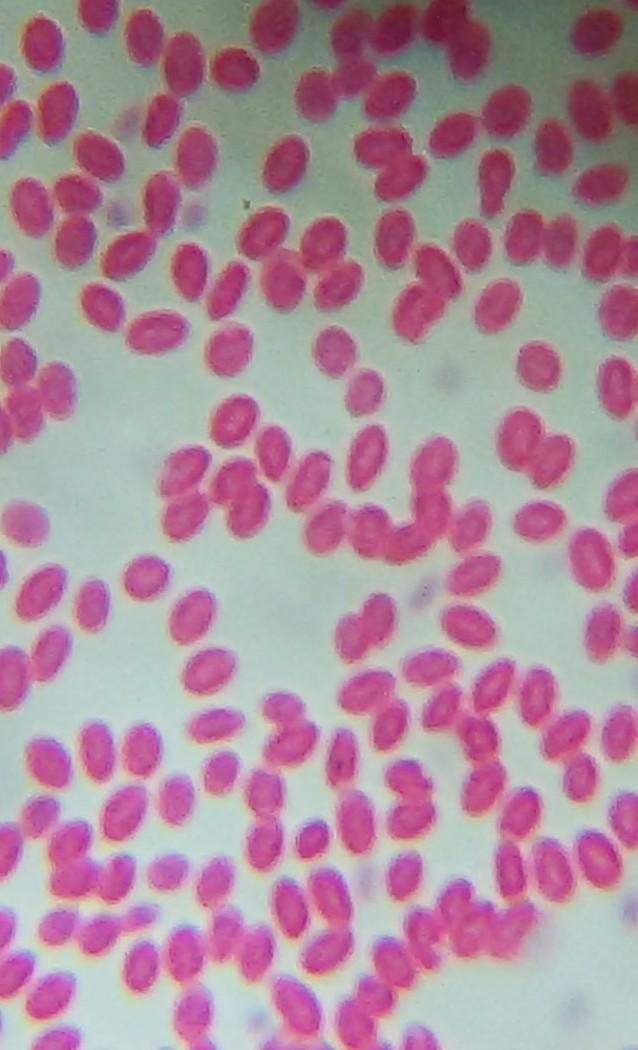

Ответы
Ответ дал:
0
Ответ:
ЩАС ТЕ ПОМОГУТ!!!!!!!!!!!!
Вас заинтересует
2 года назад
2 года назад
3 года назад
3 года назад
8 лет назад
8 лет назад
10 лет назад
10 лет назад